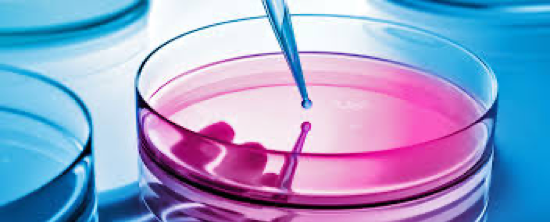

Klima- und Lüftungsgeräte als Bakterienschleuder!
Und wann war bei Ihrer Lüftung-/Klimaanlage die letzte Hygieneinspektion?
Alle Lüftungsanlagen sollten alle 2-3 Jahre einer Hygieneinspektion gemäß VDI6022 unterzogen werden, um eventuelle Verunreinigungen mittels Laboranalysen festzustellen und zu beseitigen. Diese Arbeiten sind sehr wichtig, um die Entstehung des Sick Building Syndroms zu vermeiden. Sie haben es schon erraten …
Wir sind die richtigen Ansprechpartner!

Anruf genügt …
Wir sind immer da, wenn Sie uns brauchen! Was auch passiert – rufen Sie uns einfach an! Wir sind für Sie da!
Unsere Flexibilität erlaubt es uns, rasch auf Ihre Reparaturanfragen reagieren zu können und eventuelle Gebrechen unverzüglich zu beheben. Prüfen Sie uns!
Und jetzt freuen wir uns auf Ihren Kontakt …
Denn wir möchten Sie unbedingt in Zukunft zu unseren Kunden zählen dürfen. Greifen Sie gleich jetzt zum Hörer und rufen Sie mich an!
Tel. 01/545 27 76 oder schreiben Sie mir ein Email office@dev.hagro.at.
Ich stehe Ihnen jederzeit für Ihre Fragen zur Verfügung – gerne auch persönlich und vor Ort!
Ich freue mich von Ihnen zu hören!